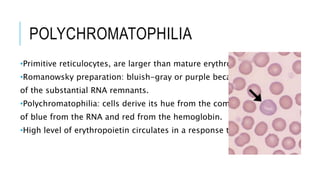
POLYCHROMATOPHILIA
•Primitive reticulocytes, are larger than mature erythrocytes.
•Romanowsky preparation: bluish-gray or purple because
of the substantial RNA remnants.
•Polychromatophilia: cells derive its hue from the combination
of blue from the RNA and red from the hemoglobin.
•High level of erythropoietin circulates in a response to anemia.

The document outlines the role of peripheral blood smears in evaluating anemia, thrombocytopenia, and abnormal cells, along with detailed techniques for preparing and staining the smears. It describes various red blood cell morphological abnormalities and inclusions that may be observed, their causes, and significance in diagnosing different conditions. Additionally, the document provides insights into the characteristics of a good smear and specific staining methods essential for accurate analysis.